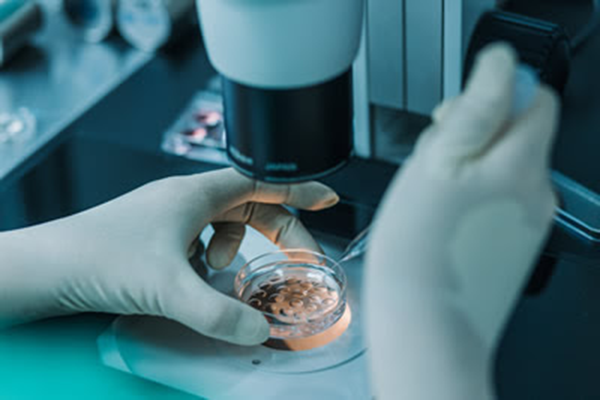

在Beta Plus,我们作为著名的试管婴儿医院很清楚地知道我们在来自世界各地成千上万的父母生命中扮演着一个非常关键的角色。我们认真地对待我们的职责,每一天都致力于做更多更有利的事情来帮助我们的准父母们,帮助他们实现他们的梦想。

我们以廉正实诚、心怀慈悲、无私奉献为根基,并且在格鲁吉亚取得了成功率高达70%至80%的优良成绩。

我们充满信心,亦相信我们有能力帮您圆梦,因此,我们满怀心喜为各位提供包成功的试管婴儿项目套餐,为许许多多在寻求可信赖解决方案的准父母提供一份精神上的平和以及压力释放的解决方案。

专业团队
我们的团队由专业的医生组建而成,他们每一位都在美国和欧洲接受了专业的培训和教育。他们当中每一个人都在试管婴儿领域拥有10年甚至超过10年的经验,所以当您将希望寄托于我们生育诊所时,您可以完全放心。

医院地址详细地址:格鲁吉亚第比利斯,0179大卫·阿格马舍内贝利巷Km12号
中文服务咨询电话:4006-777-323 微信号:spreadivf
访问更多格鲁吉亚试管助孕机构